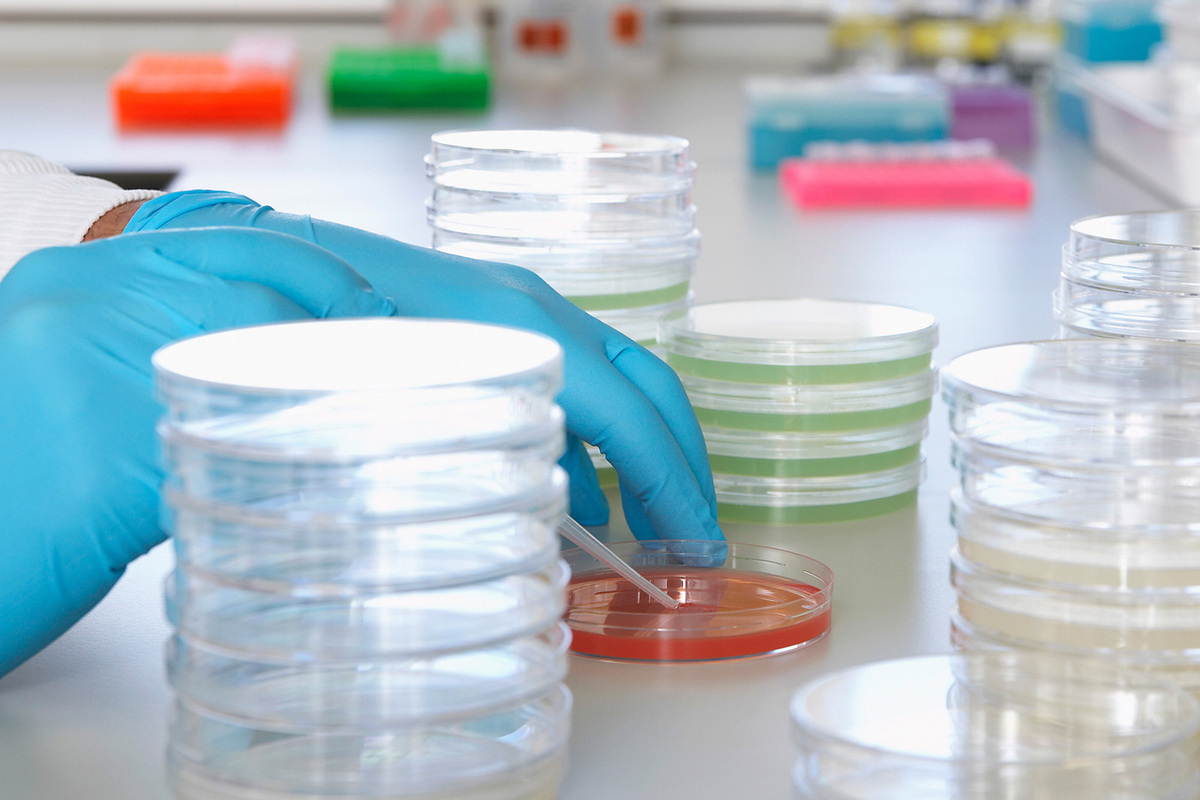
Новости - Тук-тук, кто там? Российские ученые вырастили сердце в пробирке и сняли про это научный блокбастер новости

Знаете ли вы, что за среднюю человеческую жизнь сердце совершает около 2,5 миллиардов ударов? Это, пожалуй, единственный мотор, который мы эксплуатируем без техосмотра десятилетиями, заливая в него кофе и стресс. Но что, если бы у нас была возможность вырастить «запчасть» или хотя бы посмотреть, как она работает, не вскрывая грудную клетку? Российские ученые из МФТИ решили не ждать милостей от природы и устроили настоящую магию вне Хогвартса.
Алхимия XXI века: коктейль для Бенджамина Баттона
Как говаривал профессор Преображенский: «Зачем фабриковать Спиноз, когда любая баба может его родить?». Однако наши современные светила науки пошли дальше булгаковского героя. Они не просто создают ткани, они поворачивают время вспять! ️
Представьте себе: берут у пациента обычные клетки крови, уставшие от офисной рутины, и проводят с ними сеанс радикального омоложения. Этот процесс напоминает сюжет «Загадочной истории Бенджамина Баттона»: клетки возвращаются в младенческое, эмбриональное состояние. Елена Турчанинова, младшая научная сотрудница лаборатории, объясняет это так, словно делится рецептом изысканного блюда:
«Мы имитировали естественные процессы эмбриогенеза. Подобрали точный „коктейль“ питательной среды, чтобы клетки сами организовались в миниатюрную модель сердца».
И ведь организовались! Не в легкие, не в пятку, а именно в пульсирующую сердечную ткань. Это ли не чудо дисциплины?
Кино не для всех, но ради каждого
«Видели ли вы что-то более невероятное, чем превращение одних клеток в другие? Мне всегда удивительно получить в пробирке чьё-то сердце!» — восторгается Валерия Цвелая из МФТИ. И её можно понять: это зрелище покруче спецэффектов Кэмерона.
Ученые сняли уникальный мини-фильм о жизни этих клеток в чашке Петри. Они бьются ритмично, бодро, словно маленькие барабанщики. Но кино сняли не ради «Оскара», а ради науки. На основе этой микросъемки был разработан умный алгоритм. Теперь компьютер, словно опытный кинокритик, может классифицировать клетки, распознавать фиброз (это когда ткань ленится и грубеет) и определять, здорово ли наше «сердце в банке».
Карманный дублер для ваших нервов
Для чего всё это? Нет, не для создания армии гомункулов (хотя кто знает, что там в планах на 2050 год). Главная цель — персонализированная медицина.
Представьте: у вас есть свой маленький сердечный «аватар». Врачи хотят проверить новое лекарство. Зачем рисковать вашим драгоценным организмом, если можно капнуть препарат на вашего клеточного двойника и посмотреть реакцию?
- Можно моделировать врожденные пороки в реальном времени.
- Можно создать «цифровой атлас сердца» — карту, которая будет точнее любого навигатора.
- В будущем достаточно будет крошечной биопсии, чтобы диагноз ставил искусственный интеллект, глядя на снимки, а не гадая на кофейной гуще.

Наука делает гигантские шаги, превращая фантастику в будничную реальность. Мы учимся не просто чинить человеческий «мотор», но и понимать его язык, его капризы и его тайны. И пусть сердце остается символом любви и душевных терзаний в поэзии, в лаборатории МФТИ доказали: это еще и шедевр биоинженерии, который можно воссоздать с любовью к деталям. Глядя на то, как пульсирует жизнь в простой пробирке, невольно веришь: у человечества большое и здоровое будущее. ❤️
Хотите видеть больше чудес науки и меньше скучных новостей? Заглядывайте к нам в Telegram, там пульс событий бьется еще чаще!
